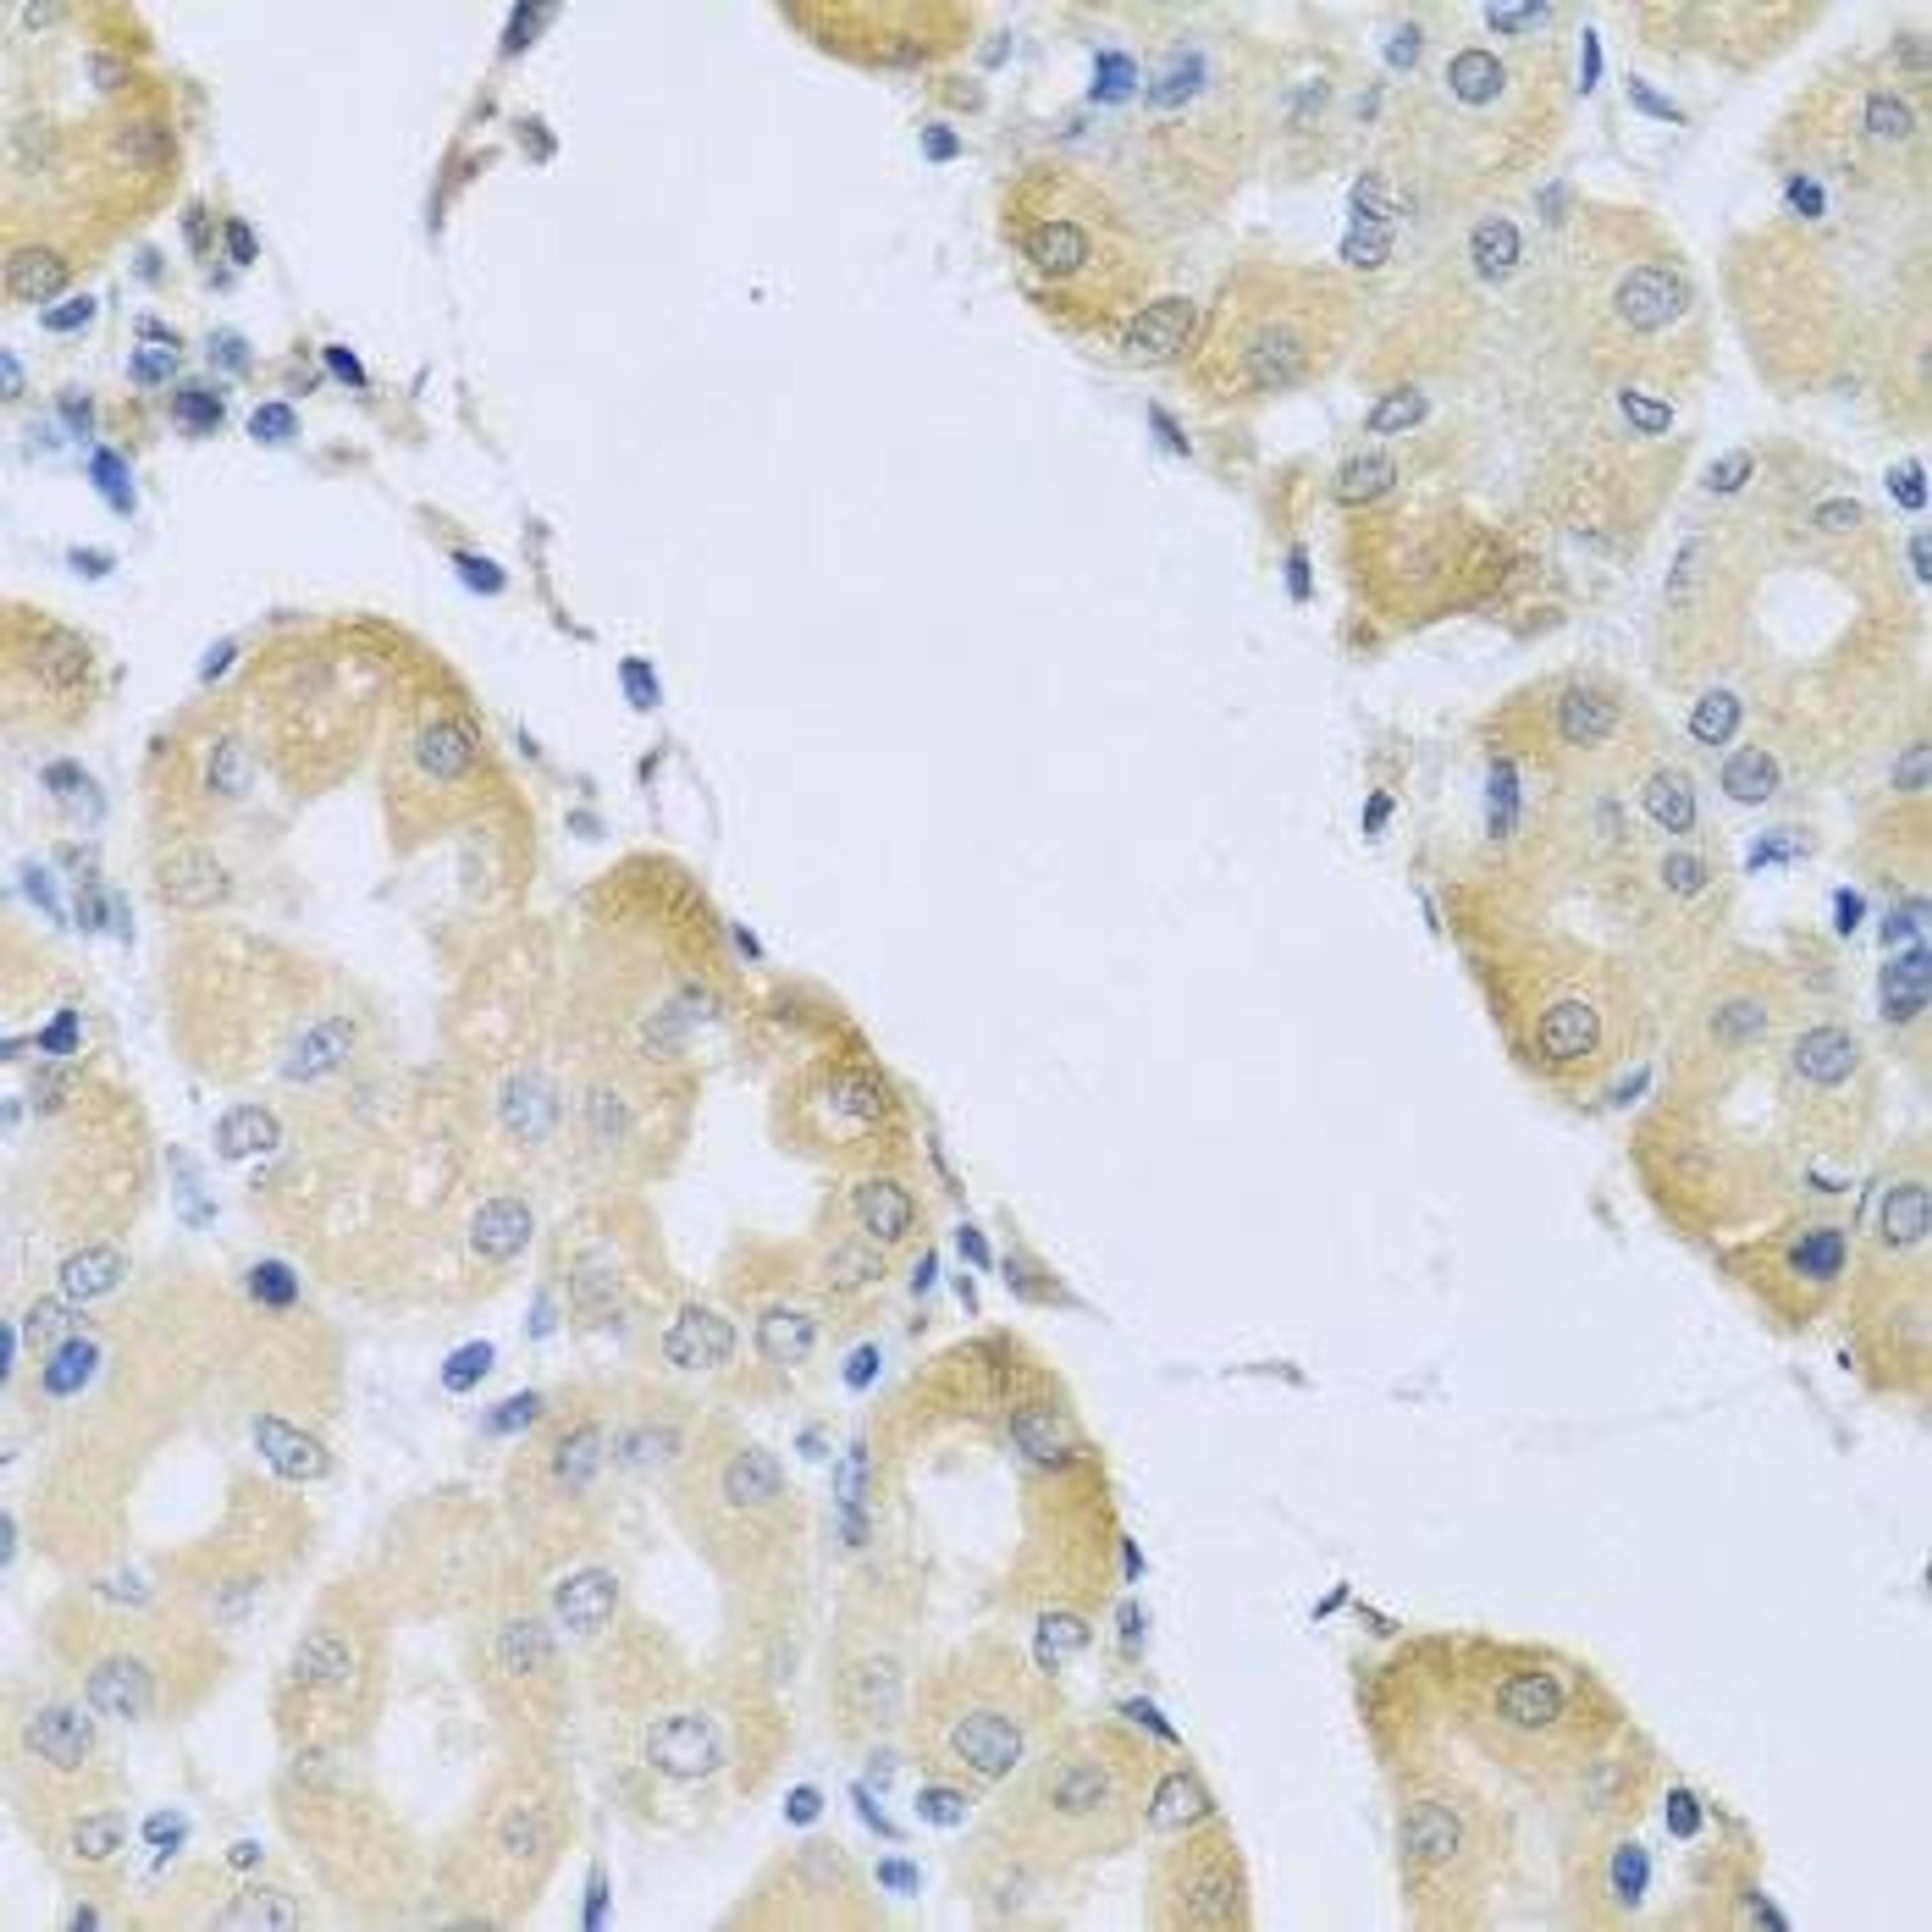
Immunohistochemical staining of mouse lung tissue using ATP2C1 antibody (dilution of 1:100)

Product & ReviewsAntibodies
LY96 antibody
Product Details
- Cat. No.
- orb136830
- Type
- Primary Antibody
- Clonality
- Polyclonal
- Host
- Rabbit

The supplier does not provide quotations for this antibody through SelectScience. You can search for similar antibodies in our Antibody Directory.
Description
Rabbit polyclonal antibody to LY96
Biological Information
- Clonality: Polyclonal
- Host: Rabbit
- Reactivity: Human, Mammalian, Mouse
- Isotype: IgG
Handling
- Quantity: 100 µg
- Storage: Store at -20°C for one year. After reconstitution, at 4°C for one month. It can also be aliquotted and stored frozen at -20°C for a longer time.Avoid repeated freezing and thawing.
- Buffer: Lyophilized. Each vial contains 5mg BSA, 0.9mg NaCl, 0.2mg Na2HPO4, 0.05mg Thimerosal, 0.05mg NaN3.
Applications
- Immunohistochemistry (Paraffin-Embedded Sections) (IHC (P))
- Western Blotting (WB)